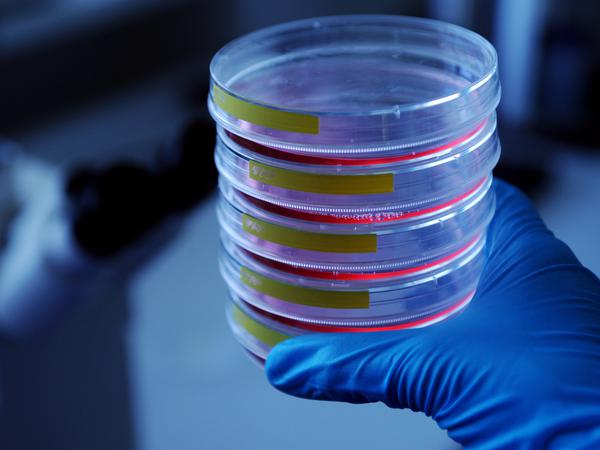

© picture alliance / Cover Images/Vesuvius Challenge/Cover Images
Studiengänge an der Freien Universität: Von alten Schriften, Bioinformatik und globaler Ungleichheit
Studieren ja, aber nicht unbedingt Jura, BWL oder Psychologie? Kein Problem: Diese besonderen Fächer werden an der Freien Universität Berlin angeboten. Eine Auswahl.
Stand:
Wie Sprache unser gesellschaftliches Zusammenleben bestimmt und wie der zwischenmenschliche Umgang unsere Sprache beeinflusst, sind Kernfragen des Bachelorstudiengangs Sprache & Gesellschaft. Neben linguistischen Pflichtmodulen untersuchen die Studierenden in Wahlmodulen das Zusammenspiel von Sprache und Macht, Kommunikation, Raum, Individuum sowie Deutsch als Fremdsprache. Das Fach ist am Interdisziplinären Zentrum Europäische Sprachen beheimatet und ist als Kombination mit philologischen Fächern ebenso geeignet wie mit sozial- oder weiteren geisteswissenschaftlichen Disziplinen.
Wem beim Gedanken an die kulturelle Entwicklung der Menschheit das Herz höher schlägt, könnte im fächerübergreifenden Master Archaeology of the Ancient World seine Bestimmung finden. Der englischsprachige Studiengang kombiniert die Klassische Archäologie mit Prähistorischer Archäologie und der Archäologie des Nahen Ostens. Studierende tauchen dabei nicht nur in die bis zu 10.000 Jahre zurückliegende Vergangenheit ein – sie erlernen auch alle Fertigkeiten, die nötig sind, um an der weiteren Erforschung dieser vergangenen Zeiten mitzuwirken.

© D. Bonatz
Einen Bogen von der Vergangenheit in die Zukunft schlägt der fächerübergreifende englischsprachige Master Digital Studies of Ancient Texts am Fachbereich Geschichts- und Kulturwissenschaften. Altorientalistik, Ägyptologie und Koptologie treffen hier aufeinander und werden von den Studierenden in die Gegenwart geholt, etwa indem sie Daten und antike Schriftsätze mithilfe von Computermodellen auswerten.
Eine vielschichtige und transdisziplinäre Sicht auf Japan, Korea und China erwerben Studierende des Masterstudiengangs Global East Asia. Das englischsprachige Programm verbindet Grundlagen und Kenntnisse aus den Fächern Koreastudien, Japanologie, Politikwissenschaft, Wirtschaft und Geschichte. Studierende können dabei ihr Verständnis für die lokale, nationale und globale Einbettung der Regionen vertiefen.

© picture alliance / ZUMAPRESS.com/Habibur Rahman
Wer im Studium einen hohen Aktualitätsbezug sucht und die berufliche Zukunft etwa in einer NGO, in der Entwicklungszusammenarbeit, bei humanitären Organisationen oder in einem Think Tank sieht, sollte den englischsprachigen Master Geographies of Global Inequalities am Fachbereich Geowissenschaften in Erwägung ziehen. Dieser betrachtet globale Ungleichheiten innerhalb regionaler und überregionaler Zusammenhänge sowie innerhalb von Abhängigkeiten und Verflechtungen von Ökonomien und Gesellschaften. Projektarbeit ist dabei ein zentraler Aspekt. Staatliche und nichtstaatliche Einrichtungen sowie Organisationen am Wissenschaftsstandort Berlin ermöglichen dabei zahlreiche Vernetzungen.
© David Ausserhofer
Auch die Berlin University Alliance (BUA) – der Verbund der Freien Universität Berlin mit der Technischen Universität Berlin, der Humboldt-Universität zu Berlin und der Charité – Universitätsmedizin Berlin im Rahmen der Exzellenzstrategie – bietet einige einzigartige Studiengänge, die Stärken der Einrichtungen bündeln: Der Bachelorstudiengang Bioinformatik etwa, den die Freie Universität gemeinsam mit der Charité anbietet, vermittelt Studierenden eine Grundqualifizierung sowohl in Mathematik, Statistik und Informatik als auch in Molekularbiologie, Biochemie und Physiologie. Studierende lernen die Analyse von und das Verständnis für medizinische und biologische Problemstellungen und lernen, sie mithilfe von Methoden und Erkenntnissen der Bioinformatik zu lösen.
Gemeinsam mit der Humboldt-Universität bietet die Freie Universität den Masterstudiengang Global History an. In diesem ergründen Studierende grenzüberschreitende Verflechtungen von Regionen und globalen Strukturen und den daraus resultierenden Umstrukturierungen der Welt. Studierende lernen mithilfe von Vergleichen, Verbindungen und Prozessen globaler Integration zu verstehen, welche Kräfte die Welt immerfort umformen.
Digitale Medienanwendungen nicht nur zu entwickeln, sondern auch ihre Auswirkungen auf Menschen und Gesellschaften zu analysieren und zu verstehen: Das erlernen Studierende des Bachelorstudiengangs Medieninformatik. Er ist eine weitere Kooperation innerhalb der BUA: Die Freie Universität vermittelt kommunikationswissenschaftliches Wissen, die Fakultät Elektrotechnik und Informatik der Technischen Universität erforderliche Kenntnisse in Mathematik, Medientechnik und Informatik. Eine Besonderheit dieses Studiengangs ist der große Anteil sozialwissenschaftlich-analytischer Inhalte.
- showPaywall:
- false
- isSubscriber:
- false
- isPaid: